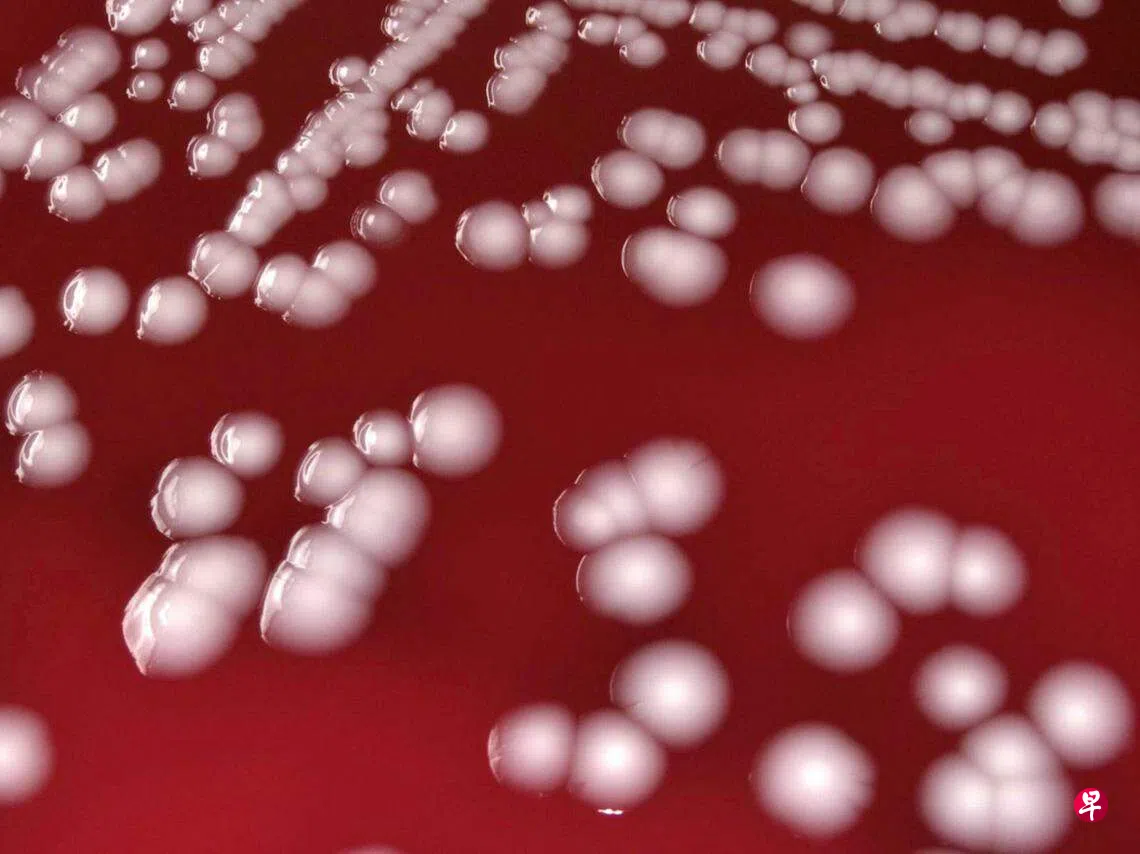

(华盛顿讯)美国和加拿大科学家利用人工智能,发现了一种能杀死致命超级细菌的全新抗生素。
根据加拿大麦克马斯特大学和美国麻省理工学院一组科学家星期四(5月25日)发表在科学杂志《自然·化学生物学》的研究报告,研究员利用人工智能演算法,筛选数以千计的抗菌分子,尝试预测新的结构类别,结果找出一种新的抗菌化合物Abaucin。
Abaucin可抑制鲍氏不动杆菌(Acinetobacter baumannii)的感染。科学家在实验鼠身上证明它对鲍氏不动杆菌的有效性。
(华盛顿讯)美国和加拿大科学家利用人工智能,发现了一种能杀死致命超级细菌的全新抗生素。
根据加拿大麦克马斯特大学和美国麻省理工学院一组科学家星期四(5月25日)发表在科学杂志《自然·化学生物学》的研究报告,研究员利用人工智能演算法,筛选数以千计的抗菌分子,尝试预测新的结构类别,结果找出一种新的抗菌化合物Abaucin。
Abaucin可抑制鲍氏不动杆菌(Acinetobacter baumannii)的感染。科学家在实验鼠身上证明它对鲍氏不动杆菌的有效性。